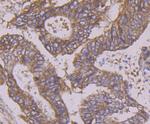
Apg3 Antibody in Immunohistochemistry (Paraffin) (IHC (P))

Search
Huabio
Apg3 Polyclonal Antibody
{{$productOrderCtrl.translations['antibody.pdp.commerceCard.promotion.promotions']}}
{{$productOrderCtrl.translations['antibody.pdp.commerceCard.promotion.viewpromo']}}
{{$productOrderCtrl.translations['antibody.pdp.commerceCard.promotion.promocode']}}: {{promo.promoCode}} {{promo.promoTitle}} {{promo.promoDescription}}. {{$productOrderCtrl.translations['antibody.pdp.commerceCard.promotion.learnmore']}}
产品信息
ER1802-71
种属反应
宿主/亚型
分类
类型
抗原
偶联物
形式
浓度
规格
纯化类型
保存液
内含物
保存条件
运输条件
靶标信息
ATG3 (APG3) is a widely expressed conjugating enzyme for APG8 lipidation, an essential step for the initiation of autophagy. Autophagy, the process of bulk degradation of cellular proteins through an autophagosomic-lysosomal pathway is important for normal growth control and may be defective in tumor cells. Autophagy is involved in the preservation of cellular nutrients under starvation conditions as well as the normal turnover of cytosolic components. This process is negatively regulated by TOR (Target of rapamycin) through phosphorylation of autophagy protein APG1. ATG3 functions as an E2-like enzyme during the initial stages of autophagosome formation by catalyzing the formation of the Atg8-phosphatidylethanolamine (Atg8-PE) conjugate, which is critical for autophagy.
仅用于科研。不用于诊断过程。未经明确授权不得转售。
篇参考文献 (0)
生物信息学
蛋白别名: APG3 autophagy 3-like; APG3-like; ATG3 autophagy related 3 homolog; autophagy-related 3; Autophagy-related protein 3; DKFZp564M1178; FLJ22125; MGC15201; Protein PC3-96; Ubiquitin-like-conjugating enzyme ATG3; unnamed protein product
基因别名: 2610016C12Rik; APG3; APG3-LIKE; APG3L; ATG3; Atg3l; hApg3; PC3-96
UniProt ID: (Human) Q9NT62, (Mouse) Q9CPX6
Entrez Gene ID: (Human) 64422, (Mouse) 67841